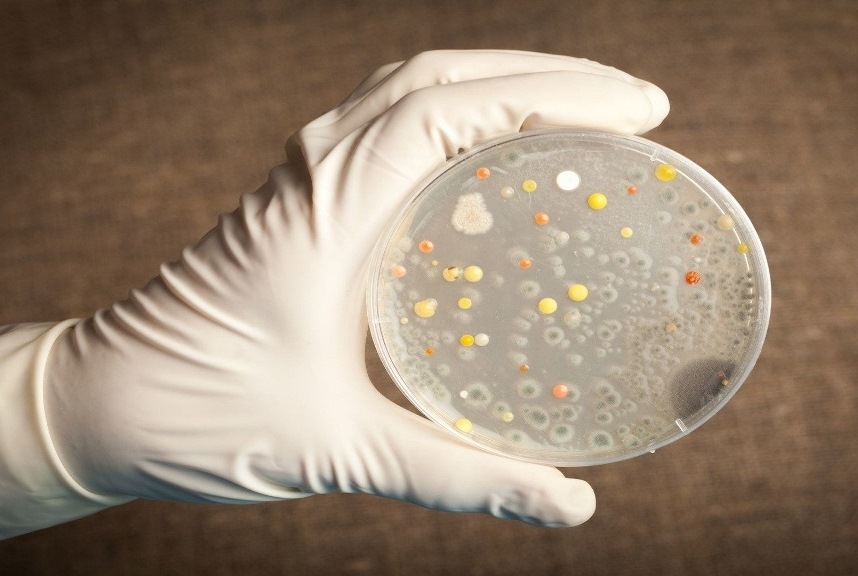

По данным Агентства по статистике при президенте Таджикистана, за 8 месяцев текущего года в стране зарегистрировано почти 19,5 тысячи случаев заражения инфекционными заболеваниями среди населения. Это на 22,2% больше, чем за аналогичный период прошлого года. С чем связано увеличение?
В ведомстве отметили, что «на долю острых вирусных гепатитов приходится 11,1% заболеваний, а острые кишечные инфекционные болезни составляют 45,2% от общего числа инфекционных заболеваний».
Однако, беспокоиться не стоит. Как отметил замначальника Управления государственного санитарно-эпидемиологического надзора Минздрава РТ Навруз Джафаров, такие цифры связаны с тем, что просто увеличилось число обращений, а также улучшилась лабораторная диагностика.
Какие это заболевания?
В первую очередь в указанный период было распространение респираторных инфекций именно в зимнее время, что вполне характерно, но резкого повышения числа заболевших не было, отметил специалист.
Дали рост и зоонозные заболевания (инфекционные заболевания, которые передаются от животных к человеку). В их числе сибирская язва. Пик заболеваемости пришелся на летний сезон. Так по состоянию на 1 июля в Таджикистане был зарегистрирован 41 случай заболевания сибирской язвой. Исключение составили только ГБАО и Раштская группа районов (кроме города Рогун). Однако ни одного летального случая за последние два года в стране не зафиксировано.
В числе заболеваний – также корь. Против кори и краснухи с 25 августа по 6 сентября этого года в стране прошли дополнительные дни иммунизации. Вакцинацию проводили среди детей в возрасте от 6 месяцев до 5 лет не только в Душанбе, но и в Вахдате, Гиссаре, районах Рудаки, Варзобе, Кубодиёне, Дангаре, Шахритусе, Кушониёне, Восе, Вахше, Фархоре Хатлонской области, а также в Пенджикенте и Исфаре Согдийской области.
«Скорее всего, заболевшие – это те, кто пропустил предыдущие кампании по вакцинации, либо болели во время их проведения. Напомним, в 2022 году у нас прошла массовая вакцинация», – отмечает специалист.

Кроме того, зимой и в начале весны имели место кишечные инфекции и вирусные гепатиты.
Вирусные гепатиты – группа инфекционно-воспалительных заболеваний печени, вызываемых разными вирусами (A, B, C, D, E), которые поражают клетки печени. Гепатиты А и Е передаются через загрязненную воду и пищу, а гепатиты В, С и D – через кровь и другие биологические жидкости. Течение болезни может быть острым, с возможным выздоровлением, или хроническим, приводящим к циррозу и раку печени.
«Те, кто заразился летом, могут заразить других людей, например, школьники, в детских садах, то есть, заражаются те, у кого не было иммунитета. И так происходит до начала октября месяца. А с середины ноября мы будем ожидать продолжение вирусного гепатита А», – говорит Джафаров.

Наибольшее количество заболевших, если сравнивать все приведенные выше болезни, дали ОРВИ, их было больше, чем в прошлом году.
В качестве мер профилактики властями проводятся санитарно-просветительские работы с населением, в школах на уроках на тему гигиены с детьми беседуют учителя. Кроме того, на темы профилактики болезней, вакцинаций, регулярно публикуются материалы в СМИ, отметил Навруз Джафаров.
Этой осенью оставайтесь с нами в Telegram, Facebook, Instagram, Яндекс.Дзен, OK и ВК





